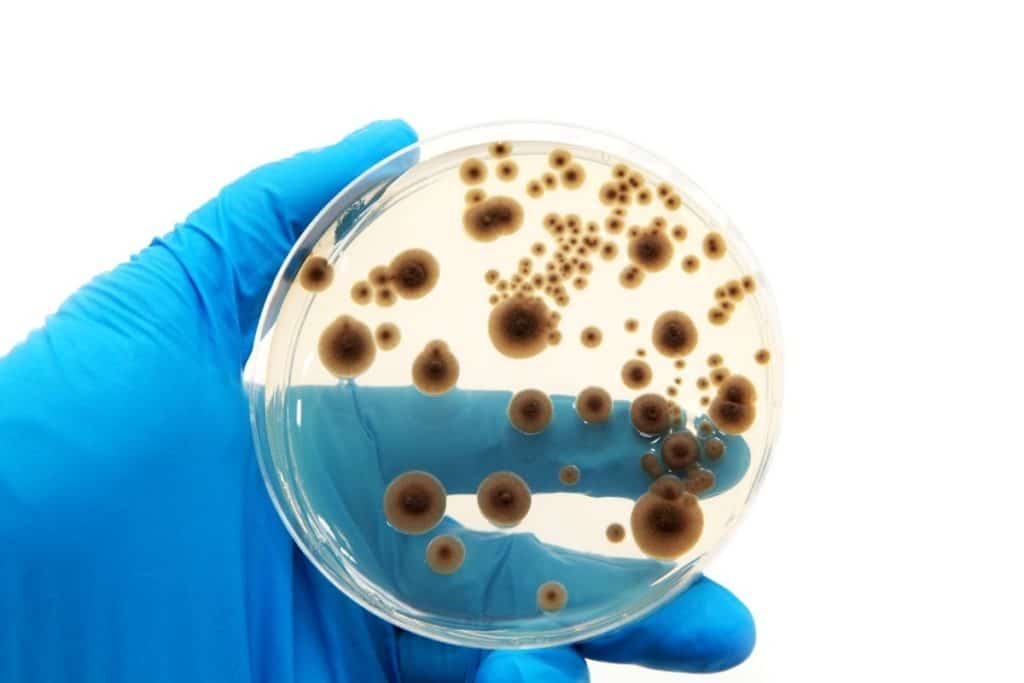
Biossoluções para a agricultura brasileira

Estudo mostra como o uso de enzimas e microorganismos pode aumentar a produtividade por hectare, reduzir a necessidade de insumos e mitigar a emissão de carbono

O mundo enfrenta uma série de desafios que impactam a vida de milhões de pessoas. Como exemplo, a mudança climática e a necessidade de se produzir cada vez mais alimentos para atender a uma população crescente. Neste contexto, a biotecnologia emerge como uma ferramenta importante. Ela pode impulsionar a produção agrícola, contribuir para a segurança alimentar e, ao mesmo tempo, reduzir o impacto ambiental. Um estudo recente lança luz sobre o potencial que as biossoluções têm na cadeia de valor agrícola do Brasil (acesse abaixo). O título do estudo é Estudo do Hectare – Desbloqueando potenciais produtivos no mesmo espaço de terra com biossoluções no país.
Biossoluções
A utilização de inoculantes, produtos compostos por grande quantidade de bactérias (as mesmas que já são encontradas no solo), assim aumentaria a produtividade das lavouras. Um exemplo é o uso do milho adicional, para a produção de 83 litros de etanol à base de amido. A soja proveniente da produção deste hectare poderia ser utilizada para a produção de 224 kg de ração rica em proteínas. Isto posto, a utilização de biossoluções no processo gera economia na aplicação de nitrogênio e de fósforo. Isso se dá devido ao uso de microrganismos que solubilizam os nutrientes, o que facilita a absorção das plantas tornando-as mais produtivas.
Além de mais produção, a adoção de biossoluções, considerando-se todos esses processos, geraria, por hectare/ano, uma redução total nas emissões de gases do efeito estufa de 1 tonelada métrica de dióxido de carbono equivalente.
O estudo então demonstra que as biossoluções representam um exemplo inspirador de como a ciência pode se unir à agricultura. Essa união visa atender às necessidades humana com menor impacto ambiental do nosso planeta. Na medida em que continuamos a desenvolver e adotar essas tecnologias, estamos um passo mais próximos de alcançar os Objetivos de Desenvolvimento Sustentável (ODS) das Nações Unidas. A aplicação das biossoluções pode ajudar a mitigar a mudança climáticas (ODS 13), produzir mais energia renovável (ODS 7), combater a fome (ODS 2) e estimular o crescimento econômico (ODS 8).
Enquanto avançamos, é essencial continuar apoiando a pesquisa e a adoção dessas soluções inovadoras. Elas têm o potencial de impactar não apenas o Brasil, mas também o mundo, pois precisamos trabalhar juntos para enfrentar os desafios ambientais e alimentares que temos diante de nós.
Fonte: Página 22
ÚLTIMAS NOTÍCIAS: SANEAMENTO: 2024 SERÁ DESAFIADOR PARA O SETOR, AVALIAM ESPECIALISTAS
ÚLTIMAS NOTÍCIAS: GERAÇÃO PRÓPRIA DE ENERGIA SOLAR CRESCE 40% EM 2023